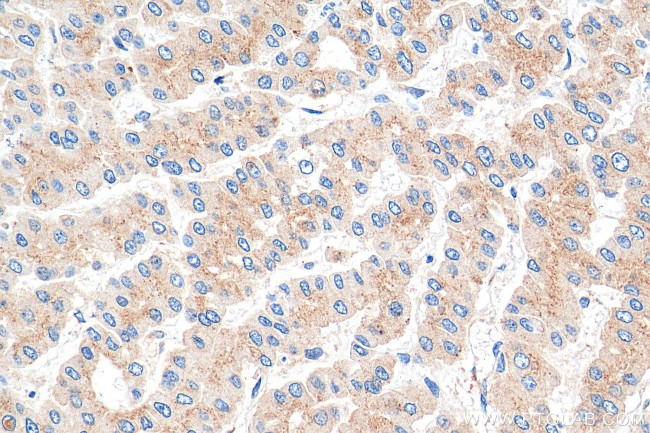
p115, USO1 Antibody in Immunohistochemistry (Paraffin) (IHC (P))

Search
Proteintech
p115, USO1 Monoclonal Antibody (3B7D8)
{{$productOrderCtrl.translations['antibody.pdp.commerceCard.promotion.promotions']}}
{{$productOrderCtrl.translations['antibody.pdp.commerceCard.promotion.viewpromo']}}
{{$productOrderCtrl.translations['antibody.pdp.commerceCard.promotion.promocode']}}: {{promo.promoCode}} {{promo.promoTitle}} {{promo.promoDescription}}. {{$productOrderCtrl.translations['antibody.pdp.commerceCard.promotion.learnmore']}}
图: 1 / 3
p115, USO1 Antibody (68100-1-IG150UL) in IHC (P)



产品信息
68100-1-IG150UL
种属反应
宿主/亚型
分类
类型
克隆号
偶联物
形式
浓度
规格
纯化类型
保存液
内含物
保存条件
运输条件
靶标信息
The protein encoded by this gene is a peripheral membrane protein which recycles between the cytosol and the Golgi apparatus during interphase. It is regulated by phosphorylation: dephosphorylated protein associates with the Golgi membrane and dissociates from the membrane upon phosphorylation. Ras-associated protein 1 recruits this protein to coat protein complex II (COPII) vesicles during budding from the endoplasmic reticulum, where it interacts with a set of COPII vesicle-associated SNAREs to form a cis-SNARE complex that promotes targeting to the Golgi apparatus. Transport from the ER to the cis/medial Golgi compartments requires the action of this gene product, GM130 and giantin in a sequential manner.
仅用于科研。不用于诊断过程。未经明确授权不得转售。
篇参考文献 (0)
生物信息学
蛋白别名: General vesicular transport factor p115; Protein USO1 homolog; TAP; transcytosis associated protein; transcytosis associated protein p115; Transcytosis-associated protein; unnamed protein product; USO1 homolog, vesicle docking protein; USO1 vesicle docking protein homolog; VDP p115; vesicle docking protein p115; vesicle docking protein, 115 kDa; Vesicle-docking protein
基因别名: 115kDa; P115; TAP; USO1; VDP
UniProt ID: (Human) O60763, (Mouse) Q9Z1Z0, (Rat) P41542
Entrez Gene ID: (Human) 8615, (Mouse) 56041, (Rat) 56042